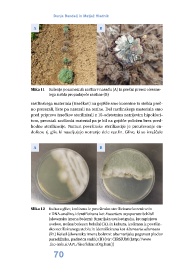

Page 70 - Laški smilj
P. 70
Dunja Bandelj in Matjaž Hladnik
A B
Slika 11 Sušenje posameznih rastlin v nasadu (A) in prečni prerez olesene-
lega stebla propadajoče rastline (B)
rastlinskega materiala (izsečkov) na gojišče smo korenine in stebla preč-
no prerezali, liste pa narezali na rezine. Del rastlinskega materiala smo
pred pripravo izsečkov sterilizirali z 10-odstotnim natrijevim hipoklori-
tom, preostali rastlinski material pa je bil na gojišče položen brez pred-
hodne sterilizacije. Namen površinske sterilizacije je preučevanje en-
dofitov, tj. gliv, ki naseljujejo notranje dele rastlin. Glive, ki so izraščale
A B
Slika 12 Kultura glive, izolirana iz površinsko sterilizirane korenine in
z DNA-analizo, identificirana kot Fusarium oxysporum Schltdl
(slovenska imena bolezni: fuzarijska uvelost graha, krompirjeva
uvelost, nožna bolezen beluša) (A), in kultura, izolirana iz površin-
sko steriliziranega stebla in identificirana kot Alternaria alternata
(Fr.) Keissl (slovenska imena bolezni: alternarijska pegavost plodov
paradižnika, padavica sadik) (B) (vir: CIRSIUM (http://www
.fito-info.si/APL/Sist/SifrantOrg.htm))
70